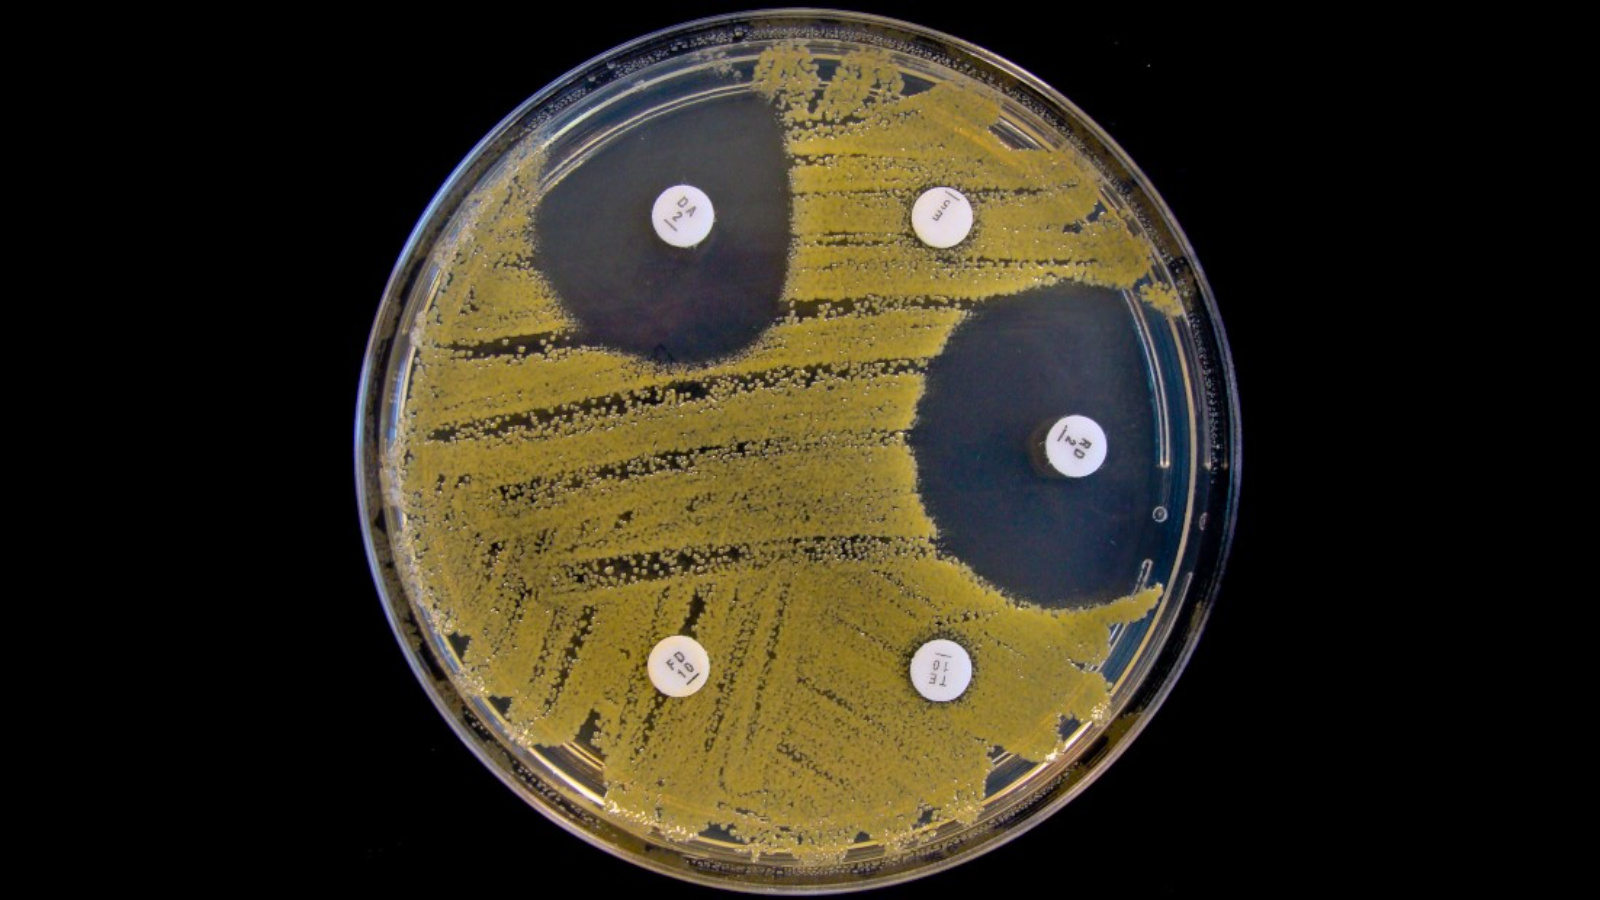

Антибиотики и устойчивость бактерий: что нужно знать каждому
В начале весны, когда отмечается Всемирный день борьбы против туберкулёза, во многих странах проходит Неделя профилактики инфекционных заболеваний. Это время напоминает нам о важности защиты здоровья и о том, что победа над инфекциями — это не только заслуга врачей, но и ответственность каждого из нас. Сегодня одной из главных угроз в борьбе с болезнями становится устойчивость бактерий к антибиотикам. Чтобы сохранить эти лекарства для будущих поколений, необходимо понимать, как они работают и почему их нельзя использовать бесконтрольно.
Природа инфекционных заболеваний
Любая инфекция — это результат столкновения нашего организма с микроскопическими захватчиками. Инфекционные заболевания возникают при воздействии болезнетворных микроорганизмов на восприимчивый к ним организм и могут передаваться от заражённого человека здоровому.
Микробы используют разные пути для распространения, и знание этих путей — основа профилактики.
Основные пути передачи инфекции и способы профилактики:
- Воздушно-капельный путь передачи (грипп, простудные заболевания, ветряная оспа, коклюш, туберкулёз, дифтерия, корь, краснуха и др.) – для профилактики используются маски, проветривание помещений, недопущение скопления большого количества людей в помещении.
- Алиментарный (пищевой) путь передачи (все кишечные инфекции, сальмонеллёз, дизентерия, вирусный гепатит А) – важную роль играет личная гигиена, мытьё рук и продуктов питания, отсутствие мух в помещениях.
- Половой путь передачи (вирусный гепатит В и С, ВИЧ-инфекция и т.д.) – важным аспектом профилактики таких инфекций является использование барьерных средств защиты.
- Кровяной путь передачи (наиболее часто – вирусный гепатит В, ВИЧ-инфекция) – в этом случае предотвратить инфекционные заболевания помогут стерильный хирургический инструментарий и отказ от татуировок (особенно в домашних условиях).
Защита от инфекций делится на два уровня. Профилактика инфекционных заболеваний включает индивидуальную (вакцинация, соблюдение правил гигиены, закаливание, ведение здорового образа жизни) и общественную профилактику (создание здоровых и безопасных условий труда и быта на производстве, на рабочем месте).
Туберкулёз: почему антибиотики перестают работать?
Туберкулёз — классический пример того, как важна правильная терапия. Это заболевание вызывается особой бактерией — микобактерией. Туберкулёз – это инфекционное заболевание, вызванное микобактерией, поражающее чаще всего лёгкие. Но палочка Коха может поражать и другие органы: лимфатическую систему, кости, суставы, мочеполовые органы, кожу, глаза и нервную систему.
Лечение туберкулёза долгое и сложное. Оно требует приёма нескольких антибиотиков одновременно в течение многих месяцев. Именно здесь кроется главная опасность. К группам риска относятся маленькие дети, пожилые люди, больные СПИД и ВИЧ-инфекцией, у которых иммунная система ослаблена.
Стандартная профилактика включает вакцинацию.Профилактикой туберкулёза является иммунизация вакциной БЦЖ. Прививку делают при отсутствии противопоказаний в роддоме. Ревакцинация проводится позже: ревакцинация против туберкулёза проводится в 6–7 лет.
Для контроля состояния здоровья необходимы регулярные проверки:
- В целях раннего выявления туберкулёза у детей до 18 лет ежегодно должна проводиться иммунодиагностика (проба Манту, Диаскинтест).
- Взрослые проходят скрининг: у взрослых проводят регулярные скрининговые флюорографические обследования, частота которых зависит от степени риска заболевания туберкулёзом.
Антибиотики: как возникает устойчивость?
Антибиотики — это мощное оружие против бактерий. Однако бактерии — живые организмы, которые умеют приспосабливаться. Когда мы принимаем антибиотик неправильно (недостаточная доза или слишком короткий курс), мы не убиваем всех микробов. Самые сильные из них выживают и передают свою устойчивость потомству. Так появляются «супербактерии», на которые не действуют никакие известные лекарства.
Это явление называется антибиотикорезистентностью. Если мы не изменим своё отношение к этим препаратам, мы рискуем вернуться в эпоху до открытия пенициллина, когда простая царапина могла стать смертельной.
Правила ответственного приёма антибиотиков
Чтобы антибиотики продолжали спасать жизни, необходимо соблюдать несколько простых правил:
- Принимайте антибиотики только по назначению врача. Не занимайтесь самолечением. Вирусы (грипп, ОРВИ) не лечатся антибиотиками.
- Строго соблюдайте режим приёма. Пейте лекарство через равные промежутки времени и обязательно закончите весь курс лечения, даже если почувствовали себя лучше через пару дней.
- Никогда не делитесь антибиотиками с другими людьми и не используйте оставшиеся таблетки при новом заболевании без консультации с врачом.
- Не требуйте у врача рецепт на антибиотики при каждом чихе. Доверьтесь профессионализму специалиста.
Неделя профилактики инфекционных заболеваний — это повод вспомнить: лучшая защита от болезней — это сильный иммунитет и ответственное отношение к своему здоровью. Профилактика всегда эффективнее и безопаснее любого лечения.
Зам главного врача по орг.-метод. работе ГАУЗ "РЦОЗ и МП" Р.И. Валиев
врач по гиг.воспитанию ГАУЗ "РЦОЗ и МП" Р.Г. Алимова